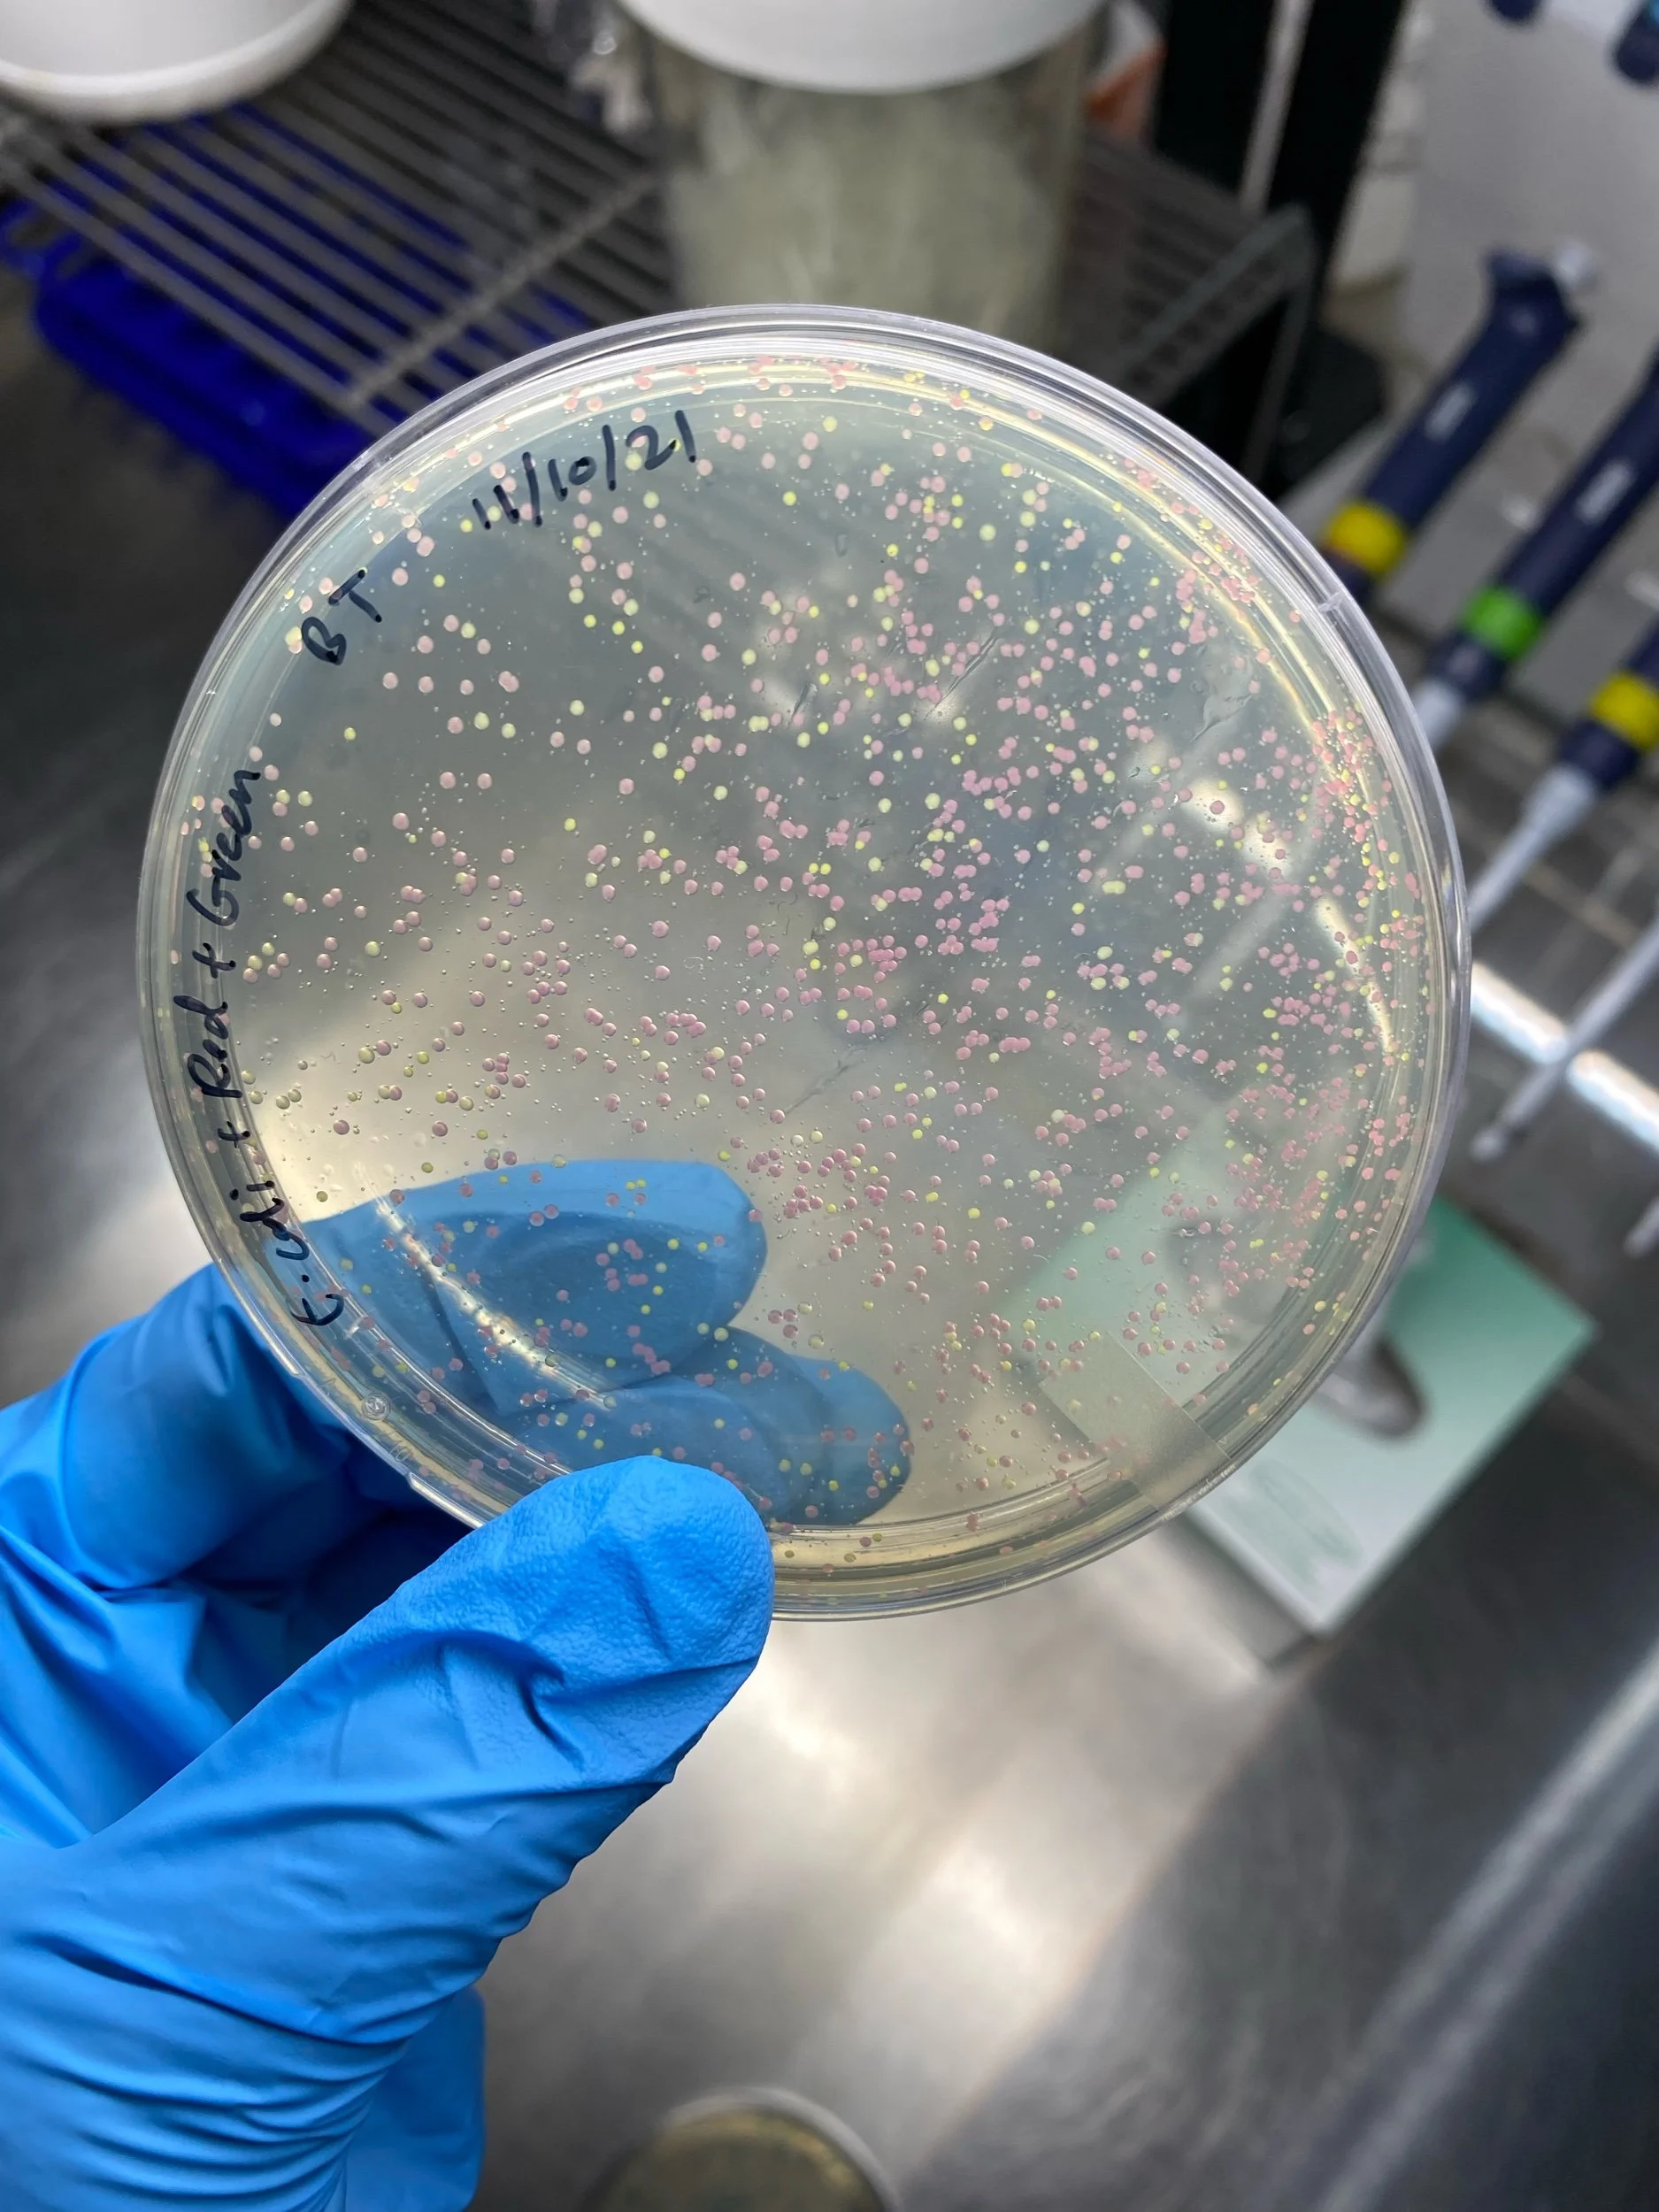
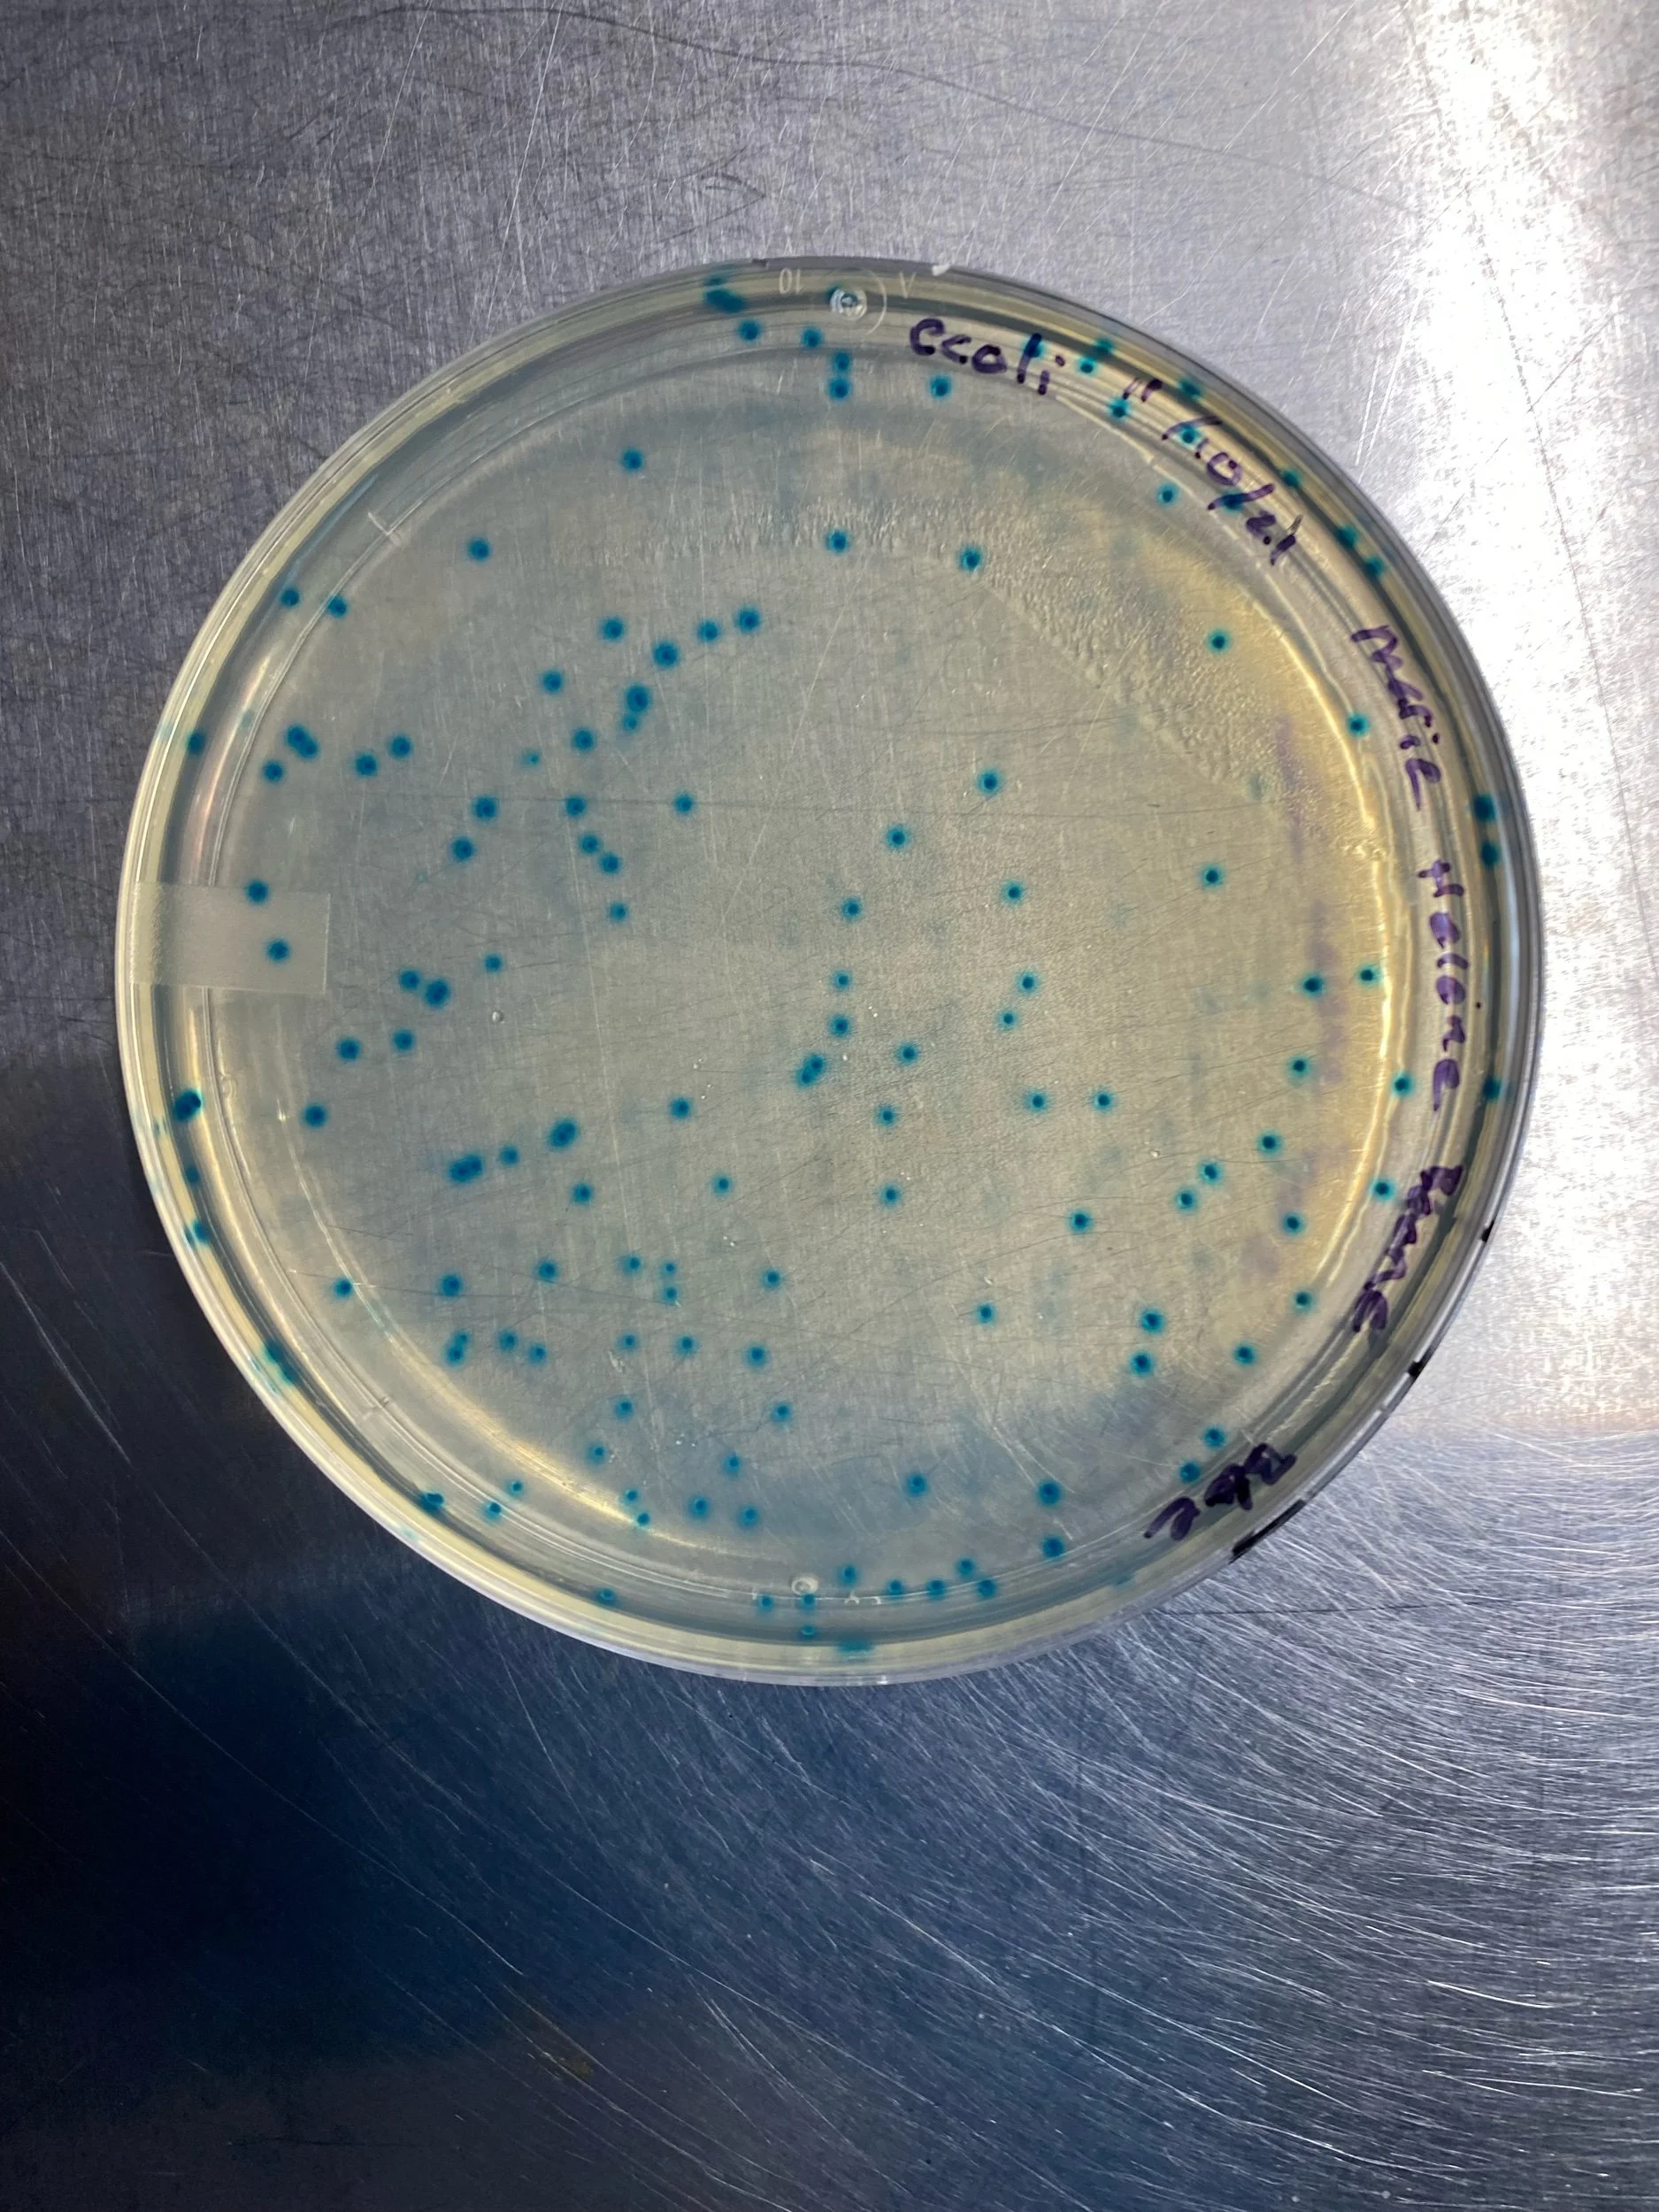

Experiment: Steel submerged in copper sulfate solution for 93 days.
Gel Electrophoresis — mitochondrial DNA isolated, DNA segment is amplified via PCR reaction — transferred into agarose gel
DNA Sequence result and cleanup processing
Experiment: Steel submerged in copper sulfate solution for 93 days.
Gel Electrophoresis — mitochondrial DNA isolated, DNA segment is amplified via PCR reaction — transferred into agarose gel
DNA Sequence result and cleanup processing